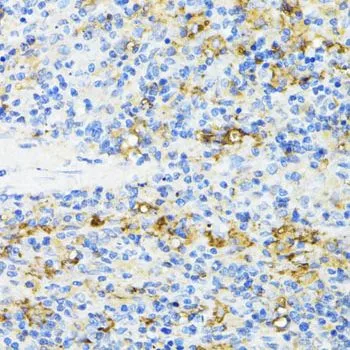

IHC-P analysis of mouse spleen tissue using GTX55555 CD27 antibody. Dilution : 1:100
CD27 antibody
GTX55555
ApplicationsImmunoFluorescence, Western Blot, ImmunoCytoChemistry, ImmunoHistoChemistry, ImmunoHistoChemistry Paraffin
Product group Antibodies
ReactivityHuman, Mouse, Rat
TargetCD27
Overview
- SupplierGeneTex
- Product NameCD27 antibody
- Delivery Days Customer9
- Application Supplier NoteWB: 1:500 - 1:2000. ICC/IF: 1:50 - 1:200. IHC-P: 1:50 - 1:200. *Optimal dilutions/concentrations should be determined by the researcher.Not tested in other applications.
- ApplicationsImmunoFluorescence, Western Blot, ImmunoCytoChemistry, ImmunoHistoChemistry, ImmunoHistoChemistry Paraffin
- CertificationResearch Use Only
- ClonalityPolyclonal
- ConjugateUnconjugated
- Gene ID939
- Target nameCD27
- Target descriptionCD27 molecule
- Target synonymsS152, S152. LPFS2, T14, TNFRSF7, Tp55, CD27 antigen, CD27L receptor, T cell activation antigen S152, T-cell activation antigen CD27, tumor necrosis factor receptor superfamily, member 7
- HostRabbit
- IsotypeIgG
- Protein IDP26842
- Protein NameCD27 antigen
- Scientific DescriptionThe protein encoded by this gene is a member of the TNF-receptor superfamily. This receptor is required for generation and long-term maintenance of T cell immunity. It binds to ligand CD70, and plays a key role in regulating B-cell activation and immunoglobulin synthesis. This receptor transduces signals that lead to the activation of NF-kappaB and MAPK8/JNK. Adaptor proteins TRAF2 and TRAF5 have been shown to mediate the signaling process of this receptor. CD27-binding protein (SIVA), a proapoptotic protein, can bind to this receptor and is thought to play an important role in the apoptosis induced by this receptor. [provided by RefSeq, Jul 2008]
- ReactivityHuman, Mouse, Rat
- Storage Instruction-20°C or -80°C,2°C to 8°C
- UNSPSC12352203

![FACS analysis of human peripheral blood lymphocytes using GTX01457-06 CD27 antibody [O323] (FITC). Solid lone : primary antibody Dashed line : isotype control antibody amount : 1 μg (5 μl)](https://www.genetex.com/upload/website/prouct_img/normal/GTX01457-06/GTX01457-06_20200428_FACS76_w_23053121_750.webp)
![FACS analysis of human peripheral blood lymphocytes using GTX01457-07 CD27 antibody [O323] (APC). Solid lone : primary antibody Dashed line : isotype control antibody amount : 0.25 μg (5 μl)](https://www.genetex.com/upload/website/prouct_img/normal/GTX01457-07/GTX01457-07_20200428_FACS14_w_23053121_165.webp)
![FACS analysis of human peripheral blood lymphocytes using GTX01457-08 CD27 antibody [O323] (PE). Solid lone : primary antibody Dashed line : isotype control antibody amount : 0.25 μg (5 μl)](https://www.genetex.com/upload/website/prouct_img/normal/GTX01457-08/GTX01457-08_20200428_FACS104_w_23053121_387.webp)
![FACS analysis of human peripheral blood lymphocytes using GTX01457-10 CD27 antibody [O323] (PE-Cy7). Solid lone : primary antibody Dashed line : isotype control antibody amount : 0.25 μg (5 μl)](https://www.genetex.com/upload/website/prouct_img/normal/GTX01457-10/GTX01457-10_20200428_FACS142_w_23053121_983.webp)
![FACS analysis of human peripheral blood lymphocytes using GTX01457-15 CD27 antibody [O323] (APC-Cy7). Solid lone : primary antibody Dashed line : isotype control antibody amount : 0.125 μg (5 μl)](https://www.genetex.com/upload/website/prouct_img/normal/GTX01457-15/GTX01457-15_20200428_FACS44_w_23053121_970.webp)
![IHC-P analysis of human mucosa from duodenum tissue using GTX04394 CD27 antibody [MSVA-027M] HistoMAX?.](https://www.genetex.com/upload/website/prouct_img/normal/GTX04394/GTX04394_20230728_IHC-P_19_23072722_482.webp)